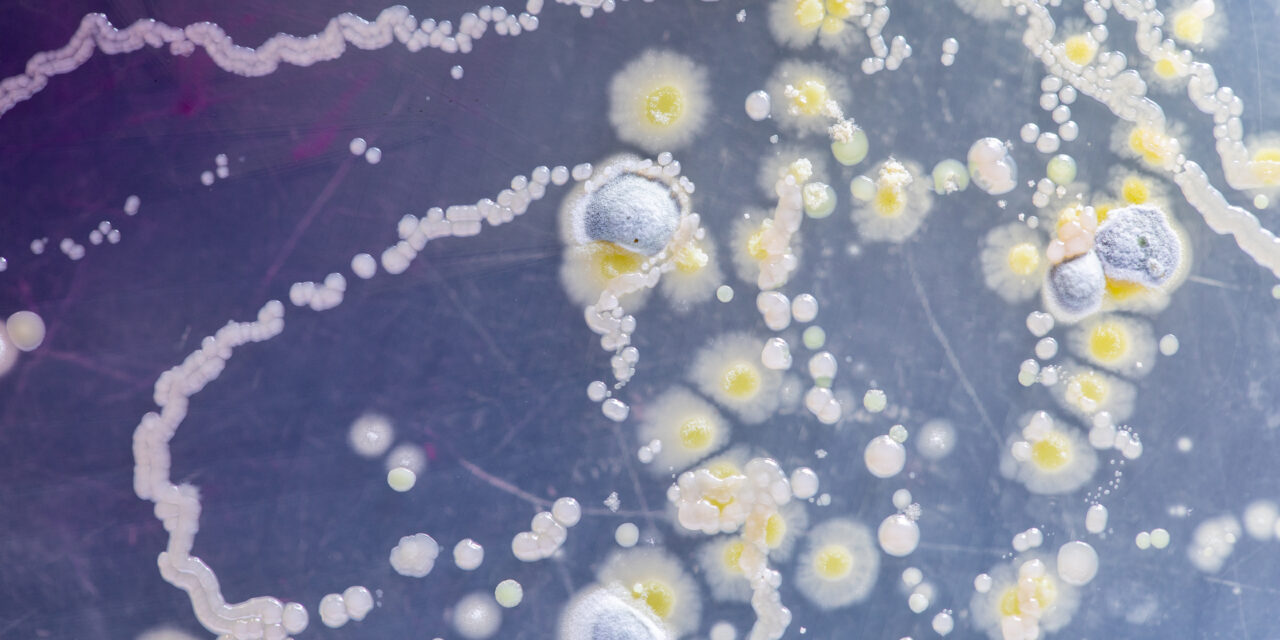
Bioweapons: Protecting Against A Silent Threat

We’ve all had infection prevention on our minds for the past few years, military leadership included. Aboard Navy ships and on military bases around the world, soldiers get sick from preventable illnesses, putting them out of commission, or worse. While there have long been infection prevention protocols in the military, the emergence of COVID-19 revealed...